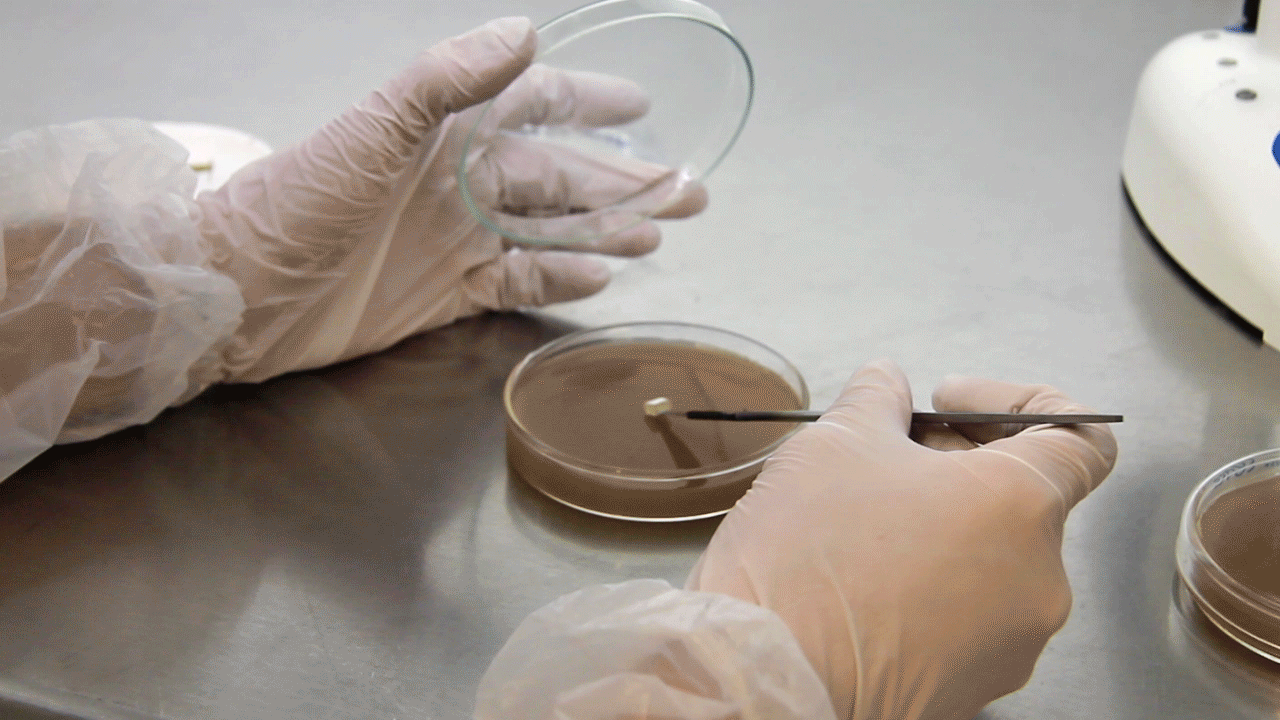

The Science of Style:
Leading the Future of Sustainable Luxury
Farm-grown from mycelium—the fibrous root structure of mushrooms—Forager AirLoom™ hides are a biobased, durable alternative to raw cow hide, offering unmatched versatility and customization. Harvested and processed in its natural form, AirLoom™ hides celebrate the beauty of structural biology while delivering the high performance required for fashion, accessories, and more.
Why AirLoom™ Hides
The Making of AirLoom™ Hides
From our AirMycelium® chambers to your finished products—watch the natural process of growing our innovative mycelium hides.

Finishes to Match Your Vision
AirLoom™ hides offer extensive flexibility in design with a wide variety of possible colors, textures, and finishes that make our materials perfect for creative and functional applications.



Glossy, matte, or iridescent finishes


Embossed patterns or natural textures


Available in custom colors tailored to your needs
Discover AirLoom™ Hides in Action
Explore how AirLoom™ hides are transforming design, from luxury handbags to cutting-edge footwear.